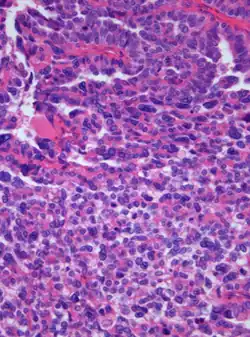

Choroid plexus carcinoma
| Choroid plexus carcinoma | |
|---|---|
![]() | |
| Photomicrograph of hematoxylin-eosin stained section of a choroid plexus carcinoma (grade III WHO) at 400x magnification | |
| Specialty | Neuro-oncology |
A choroid plexus carcinoma (WHO grade III) is a type of choroid plexus tumor[1] that affects the choroid plexus of the brain. It is considered the worst of the three grades of chord plexus tumors, having a much poorer prognosis than choroid atypical plexus papilloma (WHO grade II) and choroid plexus papilloma (WHO grade I).[2] The disease creates lesions in the brain and increases cerebrospinal fluid volume, resulting in hydrocephalus.[3]
Signs and symptoms
The symptoms of choroid plexus carcinoma are similar to those of other brain tumors. They include:[4]
- Persistent or new onset headaches
- Macrocephaly or bulging fontanels in infants.
- Loss of appetite (refusal to take food in infants)
- Papilledema
- Nausea and emesis
- Ataxia
- Strabismus
- Developmental delays
- Altered mental status
Cause
The cause of choroid plexus carcinomas are relatively unknown, although hereditary factors are suspected. They sometimes occur in conjunction with other hereditary cancers, including Li–Fraumeni syndrome and malignant rhabdoid tumors. A mutation in the tumor suppressor gene TP53 is usually characterized in this disease.[5]
Pathophysiology
Choroid plexus carcinomas typically occur in the lateral ventricles in children and in the fourth ventricle of adults. The third ventricle is the least common ventricle effected. This is unlike most other pediatric and adult tumors, as the locations of the tumors are typically reversed. These tumors are usually found in the infratentorial region in children and in the supratentorial space in adults.[6] Choroid plexus carcinomas can induce hydrocephalus through a variety of mechanisms, including blockage of normal cerebrospinal fluid (CSF) flow, the tumor overproducing CSF, spontaneous hemorrhage, and expansion of the ventricles.[7]
The tumors most frequently spread through the CSF. As a result, metastases frequently occur along the central nervous system, particularly in the leptomeninges. In rare cases, metastases have been reported to spread to the abdomen and extra-cranial sites.[8]
Diagnosis
Treatment
Treatment of choroid plexus carcinoma depends on the location and severity of the tumor. Possible interventions include inserting shunts, surgical resection, radiotherapy, and chemotherapy. Inserting a shunt could help to drain the CSF and relieve pressure on the brain. The best outcomes occur when total resection of the tumor is combined with adjuvant chemotherapy and radiotherapy.[9] In the event of subtotal resection or widespread leptomeningeal disease, craniospinal irradiation is often used.[8]
Incidence
Choroid plexus tumors have an annual incidence of about 0.3 per 1 million cases.[7] It is seen mainly in children under the age of 5,[4] representing 5% of all pediatric tumors and 20% of tumors in children less than 1 year old.[6] There has been no link between sex and occurrence.[10]
Although choroid plexus carcinomas are significantly more aggressive and have half the survival rate as choroid plexus papillomas, they are outnumbered in incidence by 5:1 in all age groups.[10][11] Clinical studies have shown that patients who receive a total resection of a tumor have an 86% survival rate, while patients who only receive a partial resection have a 26% 5-year survival rate. Many incomplete resections result in recurrence within 2 years of primary surgery.[12]
See also
References
- ^ King, David; Bison, Brigitte; Cruz, Ofelia; Faria, Claudia C.; Filipek, Iwona; Finlay, Jonathan L.; Garami, Miklós; Kordes, Uwe R.; Löbel, Ulrike; Maclean, Jilly; Mikkelsen, Torben Stamm; Obrecht-Sturm, Denise; Solanki, Guirish; Thomas, Christian; Timmerman, Beate (2025-03-18). "An overview of the European standard clinical practice recommendations for choroid plexus tumours". EJC Paediatric Oncology. 5 100226. doi:10.1016/j.ejcped.2025.100226. ISSN 2772-610X.
- ^ Stanislavsky, A (6 July 2011). "Choroid plexus carcinoma". Radiopaedia.
- ^ Adunka O, Buchman C (11 October 2010). "Management of Middle Ear Trauma". In Adunka OF, Buchman CA (eds.). Otology, Neurotology, and Lateral Skull Base Surgery: An Illustrated Handbook. Thieme. doi:10.1055/b-0034-83637. ISBN 9783131450210.
- ^ a b McEvoy AW, Harding BN, Phipps KP, Ellison DW, Elsmore AJ, Thompson D, et al. (April 2000). "Management of choroid plexus tumours in children: 20 years experience at a single neurosurgical centre". Pediatric Neurosurgery. 32 (4): 192–199. doi:10.1159/000028933. PMID 10940770. S2CID 20244382.
- ^ Dricua A, et al. (Dec 1999). DNA Methylation, Stem Cells and Cancer.
- ^ a b Rickert CH, Paulus W (January 2001). "Tumors of the choroid plexus". Microscopy Research and Technique. 52 (1): 104–111. doi:10.1002/1097-0029(20010101)52:1<104::AID-JEMT12>3.0.CO;2-3. PMID 11135453.
- ^ a b Menon G, Nair SN, Baldawa SS, Rao RB, Krishnakumar KP, Gopalakrishnan CV (May–June 2010). "Choroid plexus tumors: an institutional series of 25 patients". Neurology India. 58 (3): 429–435. doi:10.4103/0028-3886.66455. PMID 20644273.
- ^ a b Meyers SP, Khademian ZP, Chuang SH, Pollack IF, Korones DN, Zimmerman RA (September 2004). "Choroid plexus carcinomas in children: MRI features and patient outcomes". Neuroradiology. 46 (9): 770–780. doi:10.1007/s00234-004-1238-7. PMID 15309348. S2CID 22235664.
- ^ Cannon DM, Mohindra P, Gondi V, Kruser TJ, Kozak KR (January 2015). "Choroid plexus tumor epidemiology and outcomes: implications for surgical and radiotherapeutic management". Journal of Neuro-Oncology. 121 (1): 151–157. doi:10.1007/s11060-014-1616-x. PMID 25270349. S2CID 11127634.
- ^ a b Louis DN, Ohgaki H, Wiestler OD, Cavenee WK, Burger PC, Jouvet A, et al. (August 2007). "The 2007 WHO classification of tumours of the central nervous system". Acta Neuropathologica. 114 (2): 97–109. doi:10.1007/s00401-007-0243-4. PMC 1929165. PMID 17618441.
- ^ Ogiwara H, Dipatri AJ, Alden TD, Bowman RM, Tomita T (February 2012). "Choroid plexus tumors in pediatric patients". British Journal of Neurosurgery. 26 (1): 32–37. doi:10.3109/02688697.2011.601820. PMID 21970783. S2CID 12096860.
- ^ Berger C, Thiesse P, Lellouch-Tubiana A, Kalifa C, Pierre-Kahn A, Bouffet E (March 1998). "Choroid plexus carcinomas in childhood: clinical features and prognostic factors". Neurosurgery. 42 (3): 470–475. doi:10.1097/00006123-199803000-00006. PMID 9526979.